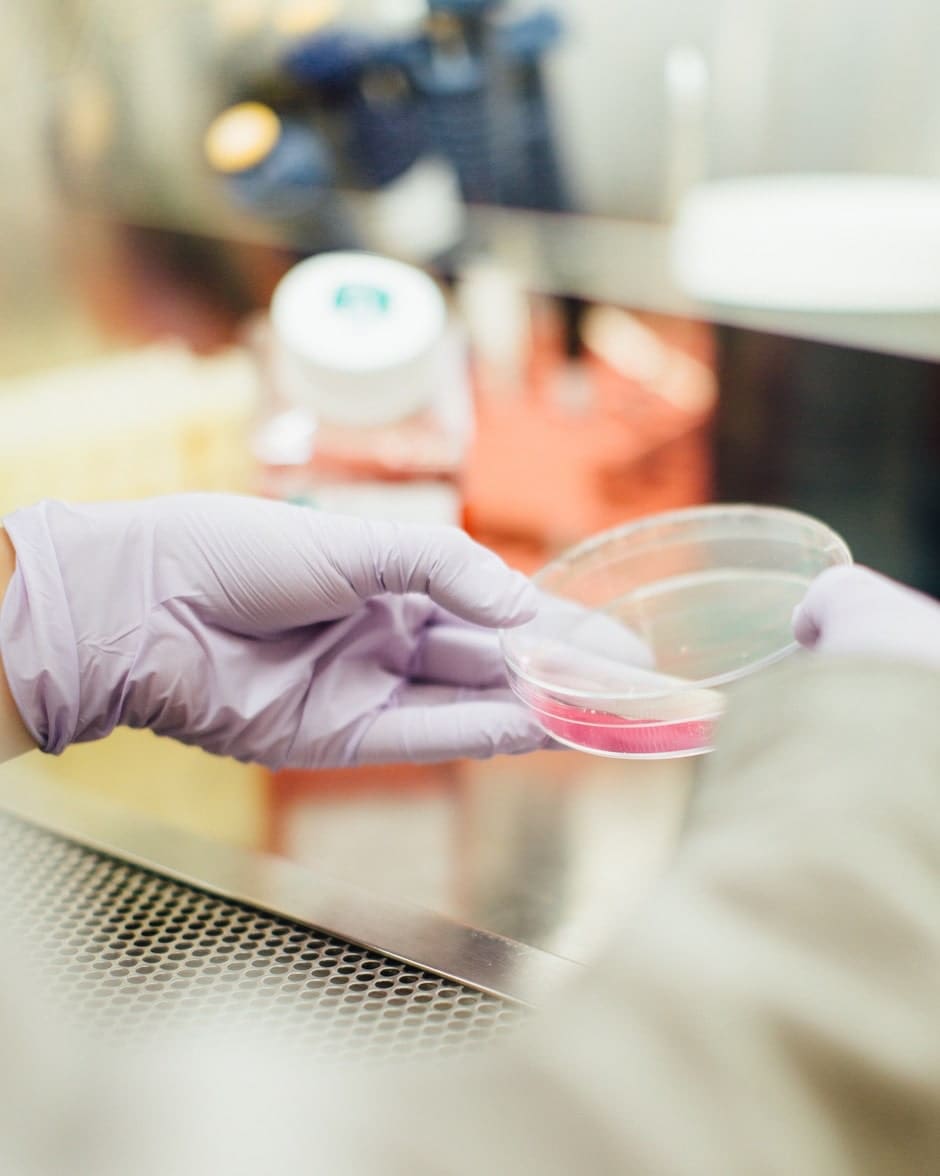
Denmark College can train you to be a stylist or a medical assistant so contact us for more information.
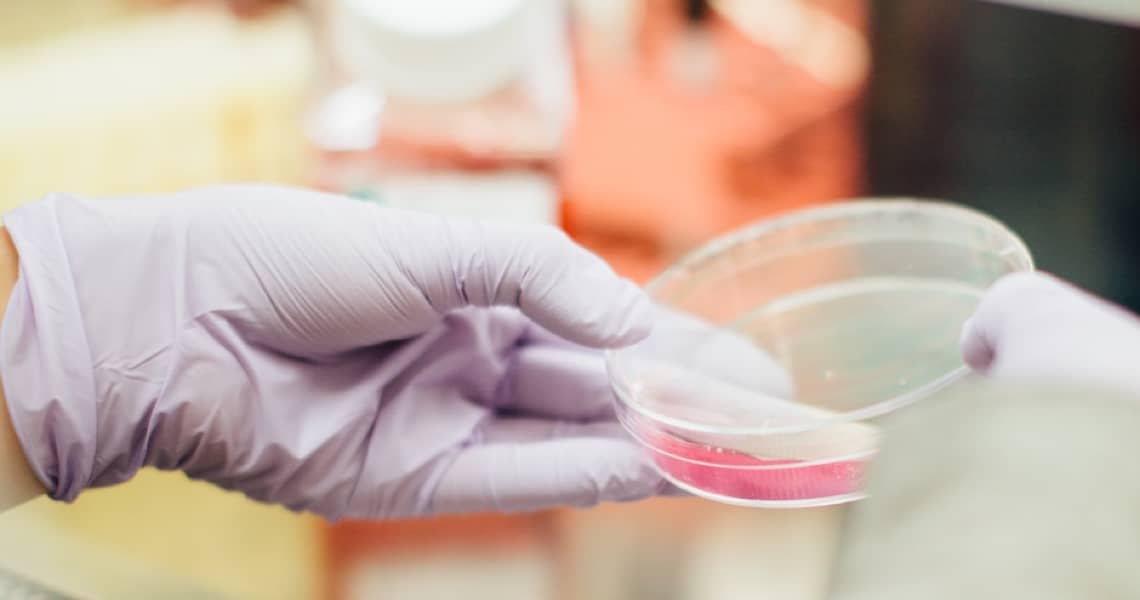
Denmark College can train you to be a stylist or a medical assistant so contact us for more information.

fund your future
An Investment In Yourself
We understand there are a lot of worries when considering a new school and career. At Denmark College, we work one-on-one with each student, every step of the way to tailor this process to you.

We Will Guide You on
Your Path to Success
Financial Aid Includes:
- Federal Pell Grants
- Federal Direct Subsidized Loans
- Federal Direct Unsubsidized Loans
- Federal Direct PLUS Loans
- Veteran’s Benefits
- Indiana Next Level Jobs Workforce Ready Grant
- Other state and federal programs for which there may be eligibility
If you would like to get a head start or learn more about your qualifications — view the Net Price Calculator.
Tuition & Fees
Select a program to see tuition and fees
Barbering

Supplies, Kit, and Tuition Costs
Full time: $21,100
Part time: $22,600
Tool kit and textbooks: These items are the sole property of the College and are loaned to each student
Part time: $22,600
Tool kit and textbooks: These items are the sole property of the College and are loaned to each student
Cosmetology

Supplies, Kit, and Tuition Costs
Full time: $21,100
Part time: $22,600
Tool kit and textbooks: These items are the sole property of the College and are loaned to each student
Part time: $22,600
Tool kit and textbooks: These items are the sole property of the College and are loaned to each student
Medical Assisting

Supplies, Kit, and Tuition Costs
Full time: $17,950
Tool kit and textbooks: These items are the sole property of the College and are loaned to each student
Tool kit and textbooks: These items are the sole property of the College and are loaned to each student
Barbering

Bringing new school to the old school
Above all else, Denmark College’s School of Barbering teaches technique. Our expertise in the blade craft reach beyond specific cuts, turning students into masters of an age-old technique and architects of today’s hair.
Helpful Resources
Frequently Asked Questions
Unlike most schools which charge separate fees for tuition, textbooks, toolkits, supplies, etc. Denmark College offers all-in pricing. Tuition for a full-time student is $21,100 for Barbering and Cosmetology and $17,950 for Medical Assistant and includes use of all textbooks, tools and supplies needed for the program.
Click on the link below to start the enrollment process or call us today at 1-844-323-2737.
Want More Info?
Connect With Us
"*" indicates required fields